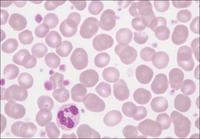

Bei extremer Mikrozytose der Erythrozyten, z.B. bei schwerer Eisenmangelanämie, können bei einer Impedanzmessung die Mikrozyten fälschlich als Thrombozyten klassifiziert und eine Thrombozytose vorgetäuscht werden. Die Bestimmung der Thrombozyten im optischen Kanal nach Anfärbung mit einem Fluoreszenzfarbstoff liefert dahingegen in einem solchen Fall immer ein korrektes Ergebnis. Das Scattergramm zeigt eine echte Thrombozytose (1.023.000/µL)

|
|
|
|